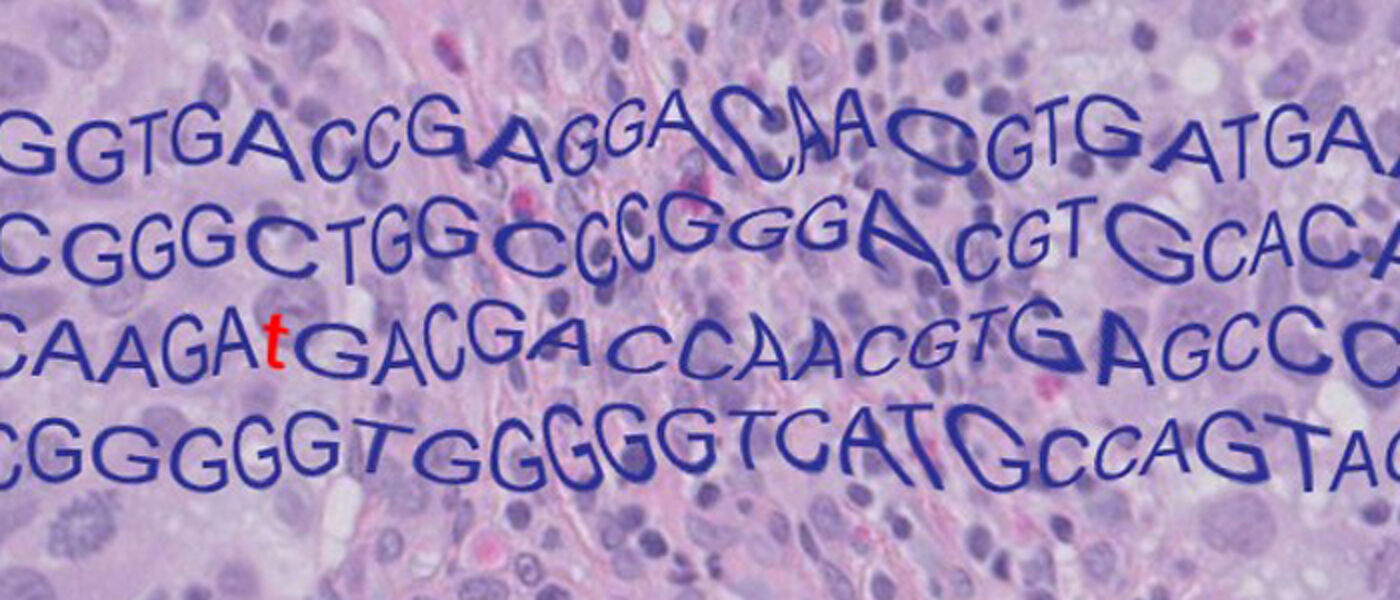

Molecular pathology

Study
- MSc/PgCert/PgDip Molecular Pathology (2016-2021)
This is a 3-year, part-time MSc programme, generated by the Glasgow Molecular Pathology Node (2016-2019). The programme aims to upskill current and future pathologists and laboratory scientists to provide molecular pathology diagnosis, and to promote their participation in research.
Research
Pathology research in Glasgow is rooted in more than 200 years of history since William Hunter’s medical collections arrived in 1783. Teaching of pathology was established at Glasgow Royal and Western Infirmaries in the 19th and 20th centuries and continues to the present day. The new Department of Pathology opened in May 2012 in Queen Elizabeth University Hospital (Southern General Hospital) is one of the largest in Europe. In August 2015, £3.4 million was awarded by MRC and EPSRC to create Glasgow Molecular Pathology Node based in our unit, with a vision to bring the Precision Medicine research into diagnostic practice. Along with University Medical Genetics, renown with excellence in teaching and research, and with Glasgow Tissue Research Facility (GTRF) with Dr Jennifer Hay as the Lab Manager, our academic unit is at the major intersection of interests between the clinical and academic staff, facilitating production of exciting and cutting-edge output in the "tissue-based" research and offering opportunities for research projects to medical and life science students.
Self-funded PhD opportunity
FGF signalling in regulation of tumour immune microenvironment
Supervisor: Dr Tomoko Iwata
Research Area: tumour immune microenvironment, growth factor signalling, molecular pathology
Project outline
Immune “cold” tumours are tumours with little infiltrations of T lymphocytes and therefore immune suppressed, developed by a mechanism of evasion from immune surveillance through cancer progression (Hallmarks of Cancer). They pose a challenge for therapy options, particularly for checkpoint inhibitors, which are otherwise promising in many cancer types. Bladder cancer is common, and one of the most highly mutated cancers, similar to lung cancer and melanoma. While potentially a preferred target of immunotherapy, the response is still limited. Recent molecular classification of muscle-invasive bladder cancer showed that FGFR3 overexpression was frequently observed in luminal-papillary subtype and non-T cell inflamed, immune cold tumours. Studies in our lab showed that activatinf FGFR3 mutation, frequently identified in bladder cancer, suppresses anti-tumour inflammation in the early stage of bladder tumour pathogenesis, thereby increasing overall frequency of tumorigenesis (1, 2). However, the mechanism of immune-suppression by FGFR3 in immune-cold subtype of bladder cancer is still unclear.
Myeloid cells, such as macrophages and neutrophils, could play anti- or pro-tumour roles depending on the stages of tumour progression. We hypothesized that sequence of signalling from myeloid cells to T cells may lead to overall immune suppression of the tumour. While suppression of anti-tumour inflammation may increase tumorigenesis, suppression of pro-tumour neutrophils may allow re-population of T cells in the tumour thereby sensitising tumours to immune checkpoint therapy. Suppression of neutrophils may also inhibit metastasis. Clinically, FGFR3 is one of the most important therapeutic targets in bladder cancer, and many drugs that target FGF signalling in cancers are already available (3). Therefore, a better understanding of the role of FGF signalling, and that of FGFR3, in regulation of tumour immune microenvironment will provide better opportunities for translation in bladder cancer and others.
Project aims
In this project, the student will investigate the spatial relationship of FGF signalling and myeloid cells in the tumour immune microenvironment in tumour tissues, and evaluate the potentials of targeting FGF signalling and myeloid cells in improving effectiveness of immunotherapy.
Technique used
The student will have opportunities to be trained in a variety of cutting-edge histopathology techniques and technologies, both lab-based and image analysis, including multispectral image analysis, special and quantitative digital pathology, immune and gene profiling, management of tissue resources of model and clinical specimens.
References
- Foth M, Ahmad I, van Rhijn BW, van der Kwast T, Bergman AM, King L, et al. Fibroblast growth factor receptor 3 activation plays a causative role in urothelial cancer pathogenesis in cooperation with Pten loss in mice. J Pathol. 2014;233(2):148-58.
- Foth M, Ismail NFB, Kung JSC, Tomlinson D, Knowles MA, Eriksson P, et al. FGFR3 mutation increases bladder tumourigenesis by suppressing acute inflammation. J Pathol. 2018;246(3):331-43.
- Ahmad I, Iwata T, Leung HY. Mechanisms of FGFR-mediated carcinogenesis. Biochim Biophys Acta. 2012;1823(4):850-60.
Contact address and email
- Tomoko.Iwata@glasgow.ac.uk
Dr Tomoko Iwata
School of Medicine, Dentistry and Nursing
Medical Genetics and Pathology, Laboratory Medicine
Queen Elizabeth University Hospital
1345 Govan Road, Glasgow G51 4TF
PI web site: https://www.gla.ac.uk/schools/medicine/staff/tomokoiwata/
https://www.gla.ac.uk/postgraduate/research/molecularpathology/
Postgraduate Research Degree Applications
After discussions with your proposed Supervisor, applications should be submitted using the University of Glasgow Online Application System. Please select the following subject title: Clinical and Surgical Sciences. Find Further information on PGR Clinical and Surgical Sciences.